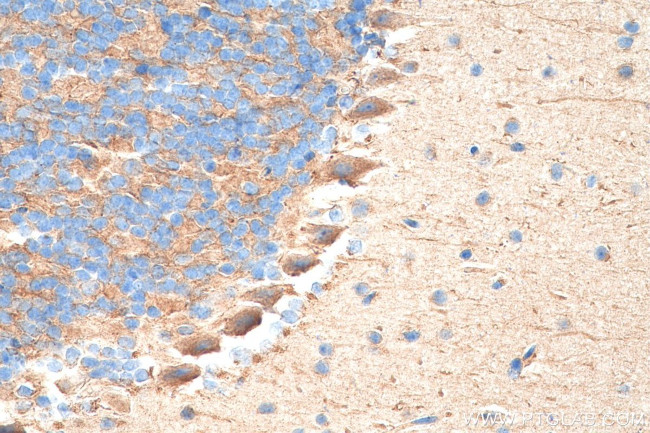
TrkB Antibody in Immunohistochemistry (Paraffin) (IHC (P))

Search
Proteintech
TrkB Polyclonal Antibody
{{$productOrderCtrl.translations['antibody.pdp.commerceCard.promotion.promotions']}}
{{$productOrderCtrl.translations['antibody.pdp.commerceCard.promotion.viewpromo']}}
{{$productOrderCtrl.translations['antibody.pdp.commerceCard.promotion.promocode']}}: {{promo.promoCode}} {{promo.promoTitle}} {{promo.promoDescription}}. {{$productOrderCtrl.translations['antibody.pdp.commerceCard.promotion.learnmore']}}
产品信息
29961-1-AP150UL
种属反应
宿主/亚型
分类
类型
偶联物
形式
浓度
规格
纯化类型
保存液
内含物
保存条件
运输条件
靶标信息
NTRK2 (TRKB) belongs to the neurotrophic factor family of related polypeptides central to the development and maintenance of the mammalian nervous system. NTRK2 is the receptor for brain-derived neurotrophic factor (BDNF). Together, NTRK2 and BDNF regulate both short-term synaptic functions and long-term potentiation of brain synapses. TrkB is involved in the development and maintenance of the nervous system. Moreover, Trk B is a tyrosine kinase gene highly related to Trk A. Trk B expression is confined to tissues within the central and peripheral nervous systems. The brain-derived neurotrophic factor (BDNF) and NT-3, but not NGF, can induce rapid phosphorylation on tyrosine of Trk B gp145, one of the receptors encoded by Trk B, although BDNF elicits a response at least two orders of magnitude greater than NT-3. TrkB is a membrane-bound receptor that, upon neurotrophin binding, phosphorylates itself and members of the MAPK pathway. Signaling through TrkB leads to cell differentiation. Mutations in the TrkB gene have been associated with obesity and mood disorders. Alternate transcriptional splice variants encoding different isoforms have been found for the TrkB gene.
仅用于科研。不用于诊断过程。未经明确授权不得转售。
篇参考文献 (0)
生物信息学
蛋白别名: AI848316; BDNF-tropomyosine receptor kinase B; BDNF/NT-3 growth factors receptor; C030027L06Rik; EC 2.7.10.1; GP145 TrkB; GP145-TrkB; GP145-TrkB/GP95-TrkB; GP145TrkB; GP95 TrkB; GP95-TrkB; hyperphagia; kinase TrkB; neural receptor protein-tyrosine kinase (trkB); Neurotrophic tyrosine kinase receptor type 2; neurotrophic tyrosine receptor kinase type 2; NTRK 2; NTRK2; OTTHUMP00000021573; OTTHUMP00000021574; OTTHUMP00000021576; OTTHUMP00000021577; Trk B; Trk-B; TrkB; TrkB tyrosine kinase; TrkB-T-Shc; Tropomyosin-related kinase B; truncated trkB; tyrosine kinase receptor B; unnamed protein product
基因别名: DEE58; EIEE58; GP145-TrkB; GP145-TrkB/GP95-TrkB; NTRK2; OBHD; RATTRKB1; Tkrb; trk-B; TRKB; TRKB1
UniProt ID: (Human) Q16620, (Mouse) P15209, (Rat) Q63604
Entrez Gene ID: (Human) 4915, (Mouse) 18212, (Rat) 25054